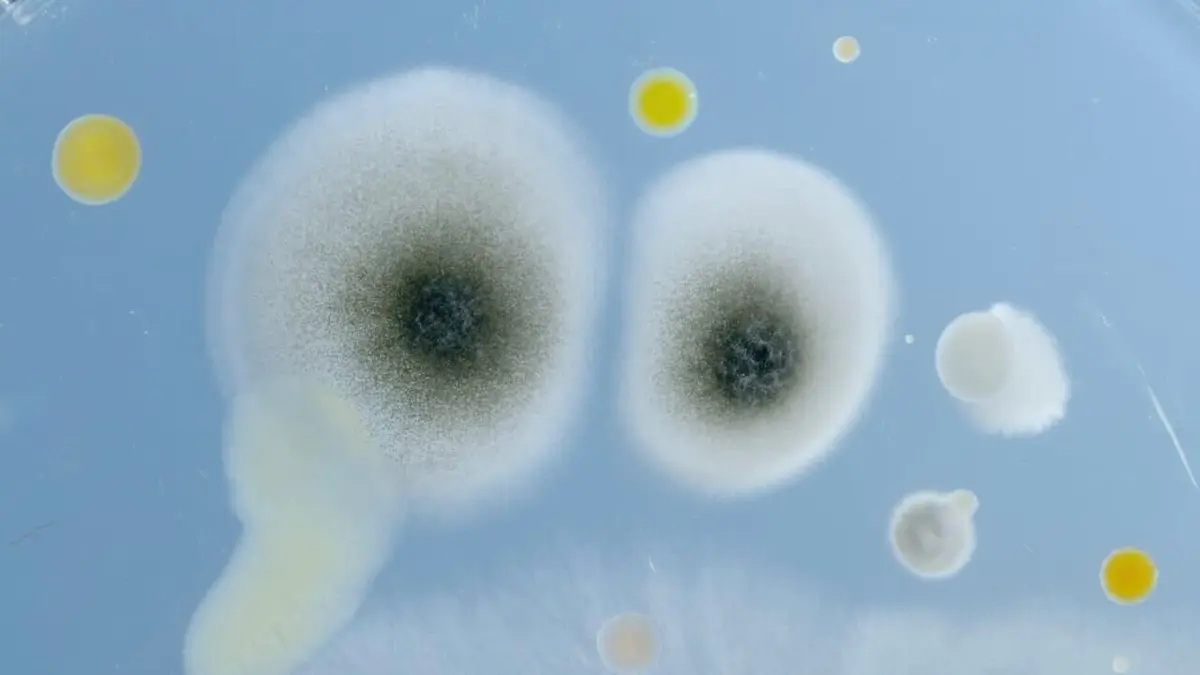
Bande annonce

Depuis quelques années, un nombre croissant de biologistes scrutent l'atmosphère terrestre, où circule une multitude de petits êtres vivants. Insectes, bactéries, virus, graines, pollens de végétaux : arrachées à la terre et aux eaux par les vents et accrochées aux poussières, ces vies minuscules peuvent effectuer de longs trajets sur de véritables autoroutes célestes. Le point sur les recherches actuelles.
Réalisé par Claude-Julie Parisot
Vidéo Le peuple des airs
Où regarder Le peuple des airs
TV : Diffusions à venir
Aucune diffusion prévue pour le moment...
DVD / Blu-ray
Dernière diffusion TV